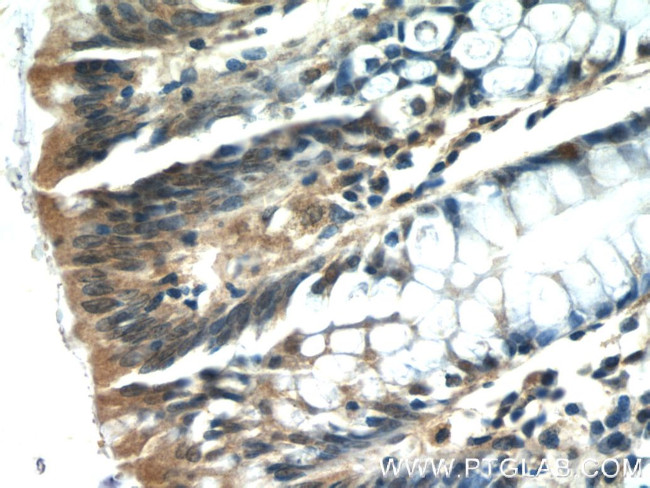
ISG20 Antibody in Immunohistochemistry (Paraffin) (IHC (P))

Search
Proteintech
ISG20 Polyclonal Antibody
{{$productOrderCtrl.translations['antibody.pdp.commerceCard.promotion.promotions']}}
{{$productOrderCtrl.translations['antibody.pdp.commerceCard.promotion.viewpromo']}}
{{$productOrderCtrl.translations['antibody.pdp.commerceCard.promotion.promocode']}}: {{promo.promoCode}} {{promo.promoTitle}} {{promo.promoDescription}}. {{$productOrderCtrl.translations['antibody.pdp.commerceCard.promotion.learnmore']}}
产品信息
22097-1-AP
种属反应
已发表种属
宿主/亚型
分类
类型
抗原
偶联物
形式
浓度
规格
纯化类型
保存液
内含物
保存条件
运输条件
产品详细信息
Immunogen sequence: MAGSREVVA MDCEMVGLGP HRESGLARCS LVNVHGAVLY DKFIRPEGEI TDYRTRVSGV TPQHMVGATP FAVARLEILQ LLKGKLVVGH DLKHDFQALK EDMSGYTIYD TSTDRLLWRE AKLDHCRRVS LRVLSERLLH KSIQNSLLGH S (1-150 aa encoded by BC007922)
靶标信息
Interferon-induced antiviral exoribonuclease that acts on single-stranded RNA and also has minor activity towards single-stranded DNA. Exhibits antiviral activity against RNA viruses including hepatitis C virus (HCV), hepatitis A virus (HAV) and yellow fever virus (YFV) in an exonuclease-dependent manner. May also play additional roles in the maturation of snRNAs and rRNAs, and in ribosome biogenesis. [UniProt]
仅用于科研。不用于诊断过程。未经明确授权不得转售。
生物信息学
蛋白别名: Estrogen-regulated transcript 45 protein; interferon stimulated exonuclease; interferon stimulated exonuclease 20; interferon stimulated exonuclease gene 20kDa; interferon stimulated gene 20kDa; Interferon-stimulated gene 20 kDa protein; interferon-stimulated protein; ISG20; low level estrogen modulated; Promyelocytic leukemia nuclear body-associated protein ISG20; Protein DnaQL
基因别名: 1600023I01Rik; 2010107M23Rik; 20kDa; CD25; DnaQL; HEM45; ISG20
UniProt ID: (Human) Q96AZ6, (Mouse) Q9JL16
Entrez Gene ID: (Human) 3669, (Mouse) 57444, (Rat) 293052